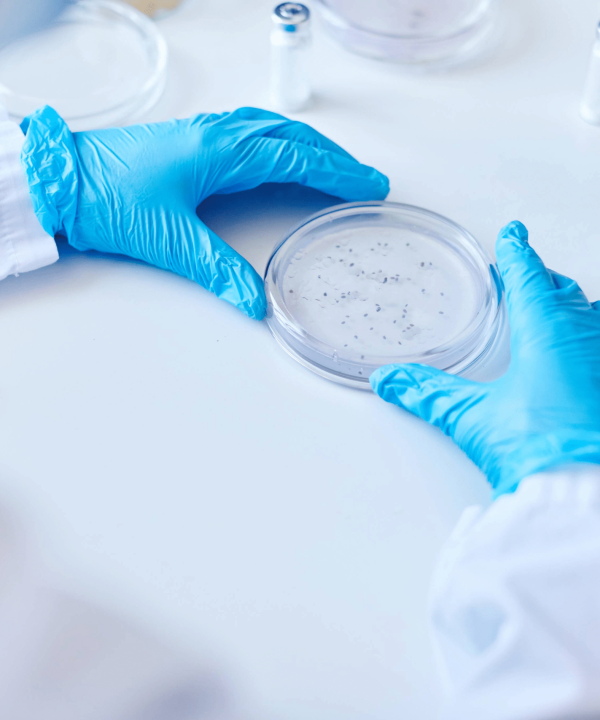
Test de charge microbienne en laboratoire chez Nano-Test.de pour contrôler la charge microbienne et la qualité des produits

Test in vivo
Les dispositifs médicaux entrent en contact direct avec le corps humain et doivent donc être soumis à des tests scientifiques avant leur mise sur le marché afin de démontrer leur innocuité biologique. Les tests in vivo sont des études expérimentales visant à évaluer les effets des dispositifs médicaux sur des organismes vivants et constituent un élément important de l'évaluation de la compatibilité biologique.
Que sont les tests in vivo ?
Le terme "in vivo" signifie "dans un organisme vivant". Cela signifie que les effets d'un dispositif médical sur les tissus, les réactions immunitaires, les niveaux de toxicité et la sécurité à long terme sont étudiés sur des animaux vivants après l'implantation dans le corps.
Ces tests sont réalisés conformément aux normes de la série ISO 10993 incluses dans notre périmètre d'analyse et font partie des tests obligatoires pour le marquage CE.
Pour quels dispositifs médicaux sont-ils nécessaires ?
- Implants (par ex. vis orthopédiques, stents, valves cardiaques)
- Dispositifs en contact avec le corps pendant une période prolongée (par exemple, cathéters, pansements)
- Produits entrant en contact avec la peau, les fluides corporels ou les muqueuses
- Dispositifs médicaux stériles et produits résorbables
Principaux types d'essais in vivo (ISO 10993)
- Test de sensibilisation - EN ISO 10993-10
- Test d'irritation - EN ISO 10993-23
- Effet hémolytique - EN ISO 10993-4
- Génotoxicité - EN ISO 10993-3
- Test d'implantation - EN ISO 10993-6
- Test de pyrogénicité - EN ISO 10993-11
- Toxicité systémique - EN ISO 10993-11
Base juridique et conformité
- ISO 10993-1 : Principes généraux de l'évaluation biologique
- MDR (EU) 2017/745 : Règlement européen sur les dispositifs médicaux
- Directives d'essai de l'OCDE (pour certaines évaluations toxicologiques)
Nous réalisons des tests in vivo pour les dispositifs médicaux dans nos installations accréditées selon la norme ISO/IEC 17025, conformément aux principes éthiques internationaux et aux dispositions légales.